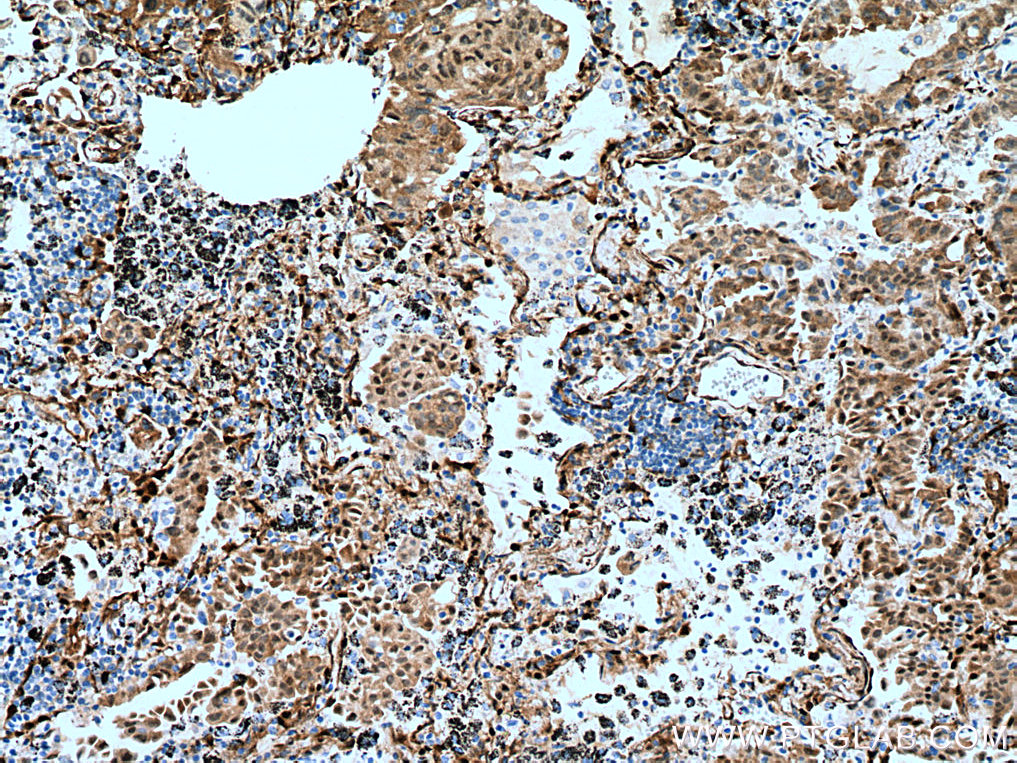
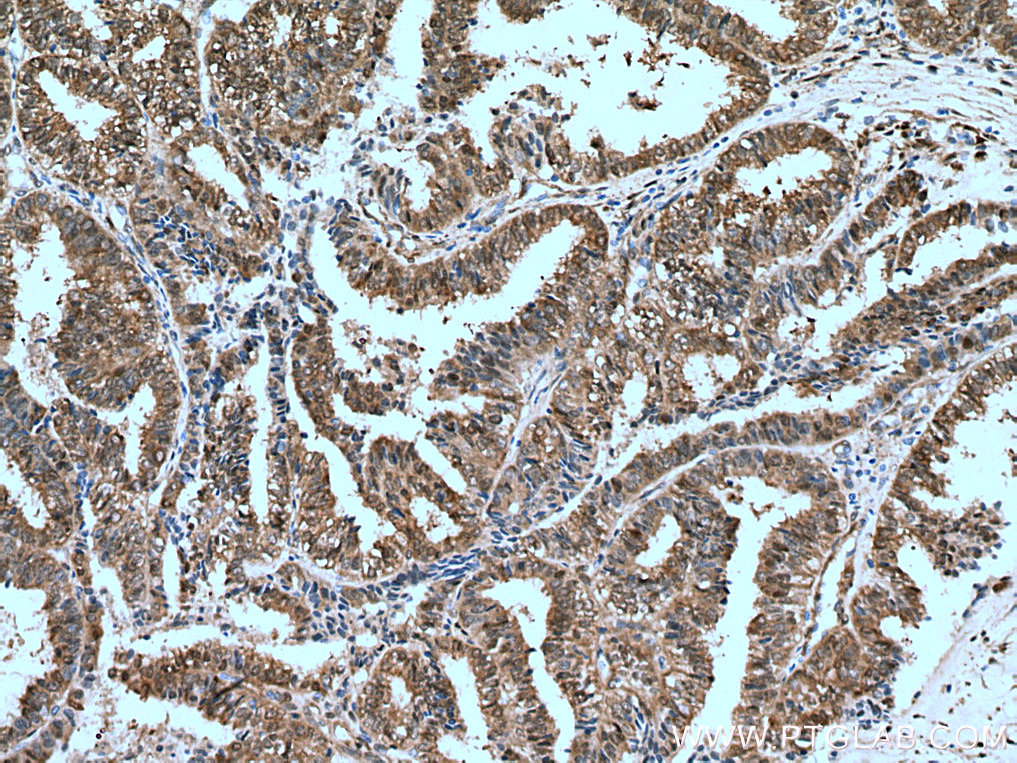

验证数据展示
经过测试的应用
| Positive WB detected in | NCI-H1299 cells, HUVEC cells, HeLa cells, HSC-T6 cells, NIH/3T3 cells, MCF-7 cells, LNCaP cells, HEK-293 cells, HepG2 cells, NIH-3T3 cells, 4T1 cells |
| Positive IHC detected in | human lung cancer tissue, human colon cancer tissue, human liver cancer tissue, human ovary tumor tissue Note: suggested antigen retrieval with TE buffer pH 9.0; (*) Alternatively, antigen retrieval may be performed with citrate buffer pH 6.0 |
| Positive IF/ICC detected in | HepG2 cells |
推荐稀释比
| 应用 | 推荐稀释比 |
|---|---|
| Western Blot (WB) | WB : 1:5000-1:50000 |
| Immunohistochemistry (IHC) | IHC : 1:1000-1:4000 |
| Immunofluorescence (IF)/ICC | IF/ICC : 1:400-1:1600 |
| It is recommended that this reagent should be titrated in each testing system to obtain optimal results. | |
| Sample-dependent, Check data in validation data gallery. | |
产品信息
66900-1-Ig targets YAP1 in WB, IHC, IF/ICC, IP, CoIP, ELISA applications and shows reactivity with human, mouse, rat samples.
| 经测试应用 | WB, IHC, IF/ICC, ELISA Application Description |
| 文献引用应用 | WB, IHC, IF, IP, CoIP |
| 经测试反应性 | human, mouse, rat |
| 文献引用反应性 | human, mouse, rat, sheep |
| 免疫原 |
CatNo: Ag28194 Product name: Recombinant human YAP1 protein Source: e coli.-derived, PET28a Tag: 6*His Domain: 155-504 aa of BC038235 Sequence: PTAQHLRQSSFEIPDDVPLPAGWEMAKTSSGQRYFLNHIDQTTTWQDPRKAMLSQMNVTAPTSPPVQQNMMNSASGPLPDGWEQAMTQDGEIYYINHKNKTTSWLDPRLDPRFAMNQRISQSAPVKQPPPLAPQSPQGGVMGGSNSNQQQQMRLQQLQMEKERLRLKQQELLRQAMRNINPSTANSPKCQELALRSQLPTLEQDGGTQNPVSSPGMSQELRTMTTNSSDPFLNSGTYHSRDESTDSGLSMSSYSVPRTPDDFLNSVDEMDTGDTINQSTLPSQQNRFPDYLEAIPGTNVDLGTLEGDGMNIEGEELMPSLQEALSSDILNDMESVLAATKLDKESFLTWL 种属同源性预测 |
| 宿主/亚型 | Mouse / IgG1 |
| 抗体类别 | Monoclonal |
| 产品类型 | Antibody |
| 全称 | Yes-associated protein 1, 65kDa |
| 别名 | yes associated protein 1, YAP, Transcriptional coactivator YAP1, Protein yorkie homolog, 65 kDa Yes associated protein |
| 计算分子量 | 504 aa, 54 kDa |
| 观测分子量 | 65-75 kDa |
| GenBank蛋白编号 | BC038235 |
| 基因名称 | YAP1 |
| Gene ID (NCBI) | 10413 |
| RRID | AB_2882229 |
| 偶联类型 | Unconjugated |
| 形式 | Liquid |
| 纯化方式 | Protein G purification |
| UNIPROT ID | P46937 |
| 储存缓冲液 | PBS with 0.02% sodium azide and 50% glycerol, pH 7.3. |
| 储存条件 | Store at -20°C. Stable for one year after shipment. Aliquoting is unnecessary for -20oC storage. |
背景介绍
Yes-associated protein 1 (YAP1) is a transcriptional regulator which can act both as a coactivator and a corepressor and is the critical downstream regulatory target in the Hippo signaling pathway that plays a pivotal role in organ size control and tumor suppression by restricting proliferation and promoting apoptosis. The core of this pathway is composed of a kinase cascade wherein STK3/MST2 and STK4/MST1, in complex with its regulatory protein SAV1, phosphorylates and activates LATS1/2 in complex with its regulatory protein MOB1, which in turn phosphorylates and inactivates YAP1 oncoprotein and WWTR1/TAZ. Plays a key role to control cell proliferation in response to cell contact. Phosphorylation of YAP1 by LATS1/2 inhibits its translocation into the nucleus to regulate cellular genes important for cell proliferation, cell death, and cell migration. The presence of TEAD transcription factors are required for it to stimulate gene expression, cell growth, anchorage-independent growth, and epithelial mesenchymal transition (EMT) induction. Isoform 2 and isoform 3 can activate the C-terminal fragment (CTF) of ERBB4 (isoform 3).Increased expression seen in some liver and prostate cancers. Isoforms lacking the transactivation domain found in striatal neurons of patients with Huntington disease (at protein level). Phosphorylation of S381 primes YAP phosphorylation by CK1δ/ɛ, resulting in activation of a phosphodegron, thus generates a binding surface that interacts with a ubiquitin ligase, and leads to degradation by ubiquitination. (PMID: 20048001). The calcualted molecular weight of YAP1 is 54 kDa, but routinely observed at 65-75 kDa by Western Blot (PMID: 28230103, 33264286, 36255405).
实验方案
| Product Specific Protocols | |
|---|---|
| IF protocol for YAP1 antibody 66900-1-Ig | Download protocol |
| IHC protocol for YAP1 antibody 66900-1-Ig | Download protocol |
| WB protocol for YAP1 antibody 66900-1-Ig | Download protocol |
| Standard Protocols | |
|---|---|
| Click here to view our Standard Protocols |
发表文章
| Species | Application | Title |
|---|---|---|
Mol Cancer Co-transcriptional R-loops-mediated epigenetic regulation drives growth retardation and docetaxel chemosensitivity enhancement in advanced prostate cancer | ||
Nat Commun Endothelial discoidin domain receptor 1 senses flow to modulate YAP activation | ||
Nat Commun Fusobacterium nucleatum reduces METTL3-mediated m6A modification and contributes to colorectal cancer metastasis.
| ||
Cancer Lett A novel antagonist of the CCL5/CCR5 axis suppresses the tumor growth and metastasis of triple-negative breast cancer by CCR5-YAP1 regulation
| ||
Acta Pharmacol Sin Adaptor protein CEMIP reduces the chemosensitivity of small cell lung cancer via activation of an SRC-YAP oncogenic module |